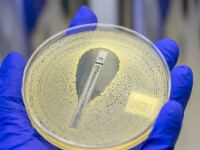
antibiotic

Cine este importatorul gunoiului descoperit în Portul Constanța. Traseul deșeurilor
Vineri 21 Februarie 2020
Anchetă de amploare în Portul Constanța Sud Agigea, unde polițiștii de frontieră și procurorii au descoperit zeci ...
Citeste mai mult ›
Citeste mai mult ›